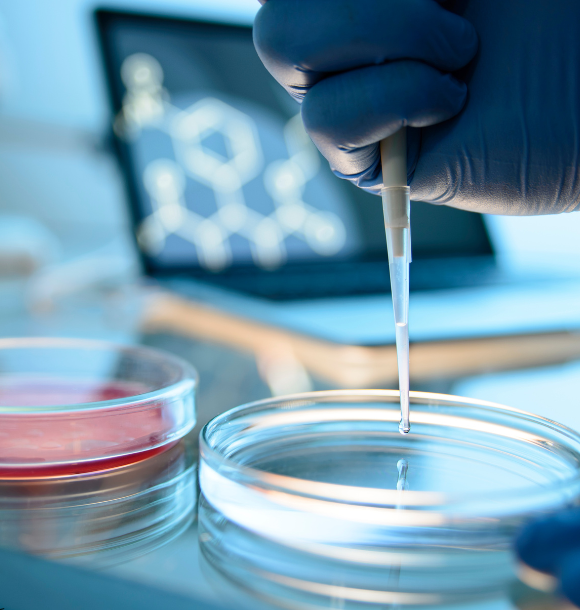

Accelerating ageing therapeutics discovery using humanised in vitro models
We offer novel scalable screening assays that identify anti-ageing compounds using phenotypic readouts from patient-relevant cells. This enables faster, target-agnostic discovery of longevity interventions.

ABOUT US
Where Ageing Science Meets Discovery
We are a research group at Newcastle University working on understanding the root causes of human ageing.
After over a decade of foundational work and several contract research projects with industry we are now transitioning towards offering a commercial Contract Research Organization (CRO). We offer an ‘ageing in a dish’ model that provides human-relevant drug-discovery screening and data for companies working in the longevity and age-related disease sectors.
THE PROBLEM
Ageing Drug Discovery is Stuck in the Past
Drug discovery for ageing and age-related diseases is held back by outdated, non-human screening models. These models slow down development and fail to predict real-world results – leading to wasted time, missed opportunities, and costly failures.
Outdated Models
Most early-stage screens rely on short-lived invertebrates like C. elegans, which don’t accurately represent human biology – especially for complex ageing pathways.
Poor Predictive Power
These non-human models often fail to translate into clinical success, leading to expensive late-stage failures in drug pipelines.
Slower Discovery Timelines
Lack of fast, human-relevant assays means it can take months just to get initial readouts – delaying R&D decisions and increasing burn rates.
Help Shape the Future of Human Ageing Research
We’re gathering insights from innovators in biotech, pharma, skincare, and nutraceuticals to better understand the challenges and needs in early-stage anti-ageing discovery.
OUR SOLUTION
Smarter Ageing Drug Discovery Starts with Humans
Human-Relevant “Ageing in a Dish”
Our assays use cells from aged human donors to directly capture age-related cellular phenotypes. This allows for both target-specific and target-agnostic screening by measuring functional rejuvenation – not just molecular markers.
Quantified Rejuvenation, Backed by Data
We deliver a clear Rejuvenation Index and full supporting data packages so companies can see whether their compounds genuinely reverse the ageing of human cells – with measurable, actionable results.
From Target to Translation
Whether you’re identifying new targets or validating existing ones, our platform is built to work across the full anti-ageing discovery pipeline – reducing risk and accelerating your path to human-relevant outcomes.

The Team Behind Ageonix Biosciences
Blending academic rigour with industry-ready innovation in human ageing science.

Dr Edward Fielder
Entrepreneurial Lead
Edward earned his PhD at Newcastle University, researching how cellular senescence drives brain ageing. He has expertise in both in vitro and in vivo models, and has contributed to multiple industry collaborations in ageing drug discovery and screening platform development.
Since joining Dr. VK’s team in 2023, he has been instrumental in developing the novel human ageing assay. He is currently participating in the ICURe Discover programme

Prof Viktor Korolchuk
Senior Academic
VK earned his PhD in Biochemistry in Kyiv and completed postdoctoral research at Bristol and Cambridge, studying cell signalling and intracellular trafficking. Since 2011, he has led research into age-related diseases like Parkinson’s and developed phenotypic assays for high-throughput screening.
He now focuses on building a drug discovery platform to support biotech spinouts and industry partnerships
Have Questions? Get in touch!
Whether you’re exploring ageing interventions or seeking data-driven screening tools, our team is here to help.
